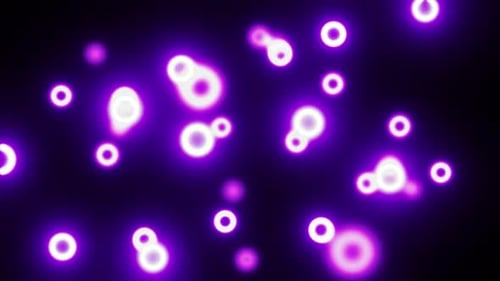
Purple Neon Abstract Circles Background Loop

Floating Purple Glowing Particles Abstract Motion Background
By VTechnoKOne great value subscription from $16.50/month
- Unlimited downloads of 27+ million creative assets
- AI Tools: video, image and more
- Lifetime commercial license
- Easy cancellation
- Length
- 0:20
- Resolution
- 2560 x 1440
- File Size
- 287 MB
- Frame Rate
- 60 fps
- Alpha Channel
- No
- Looped
- No
- Video Encoding
- H.264
- Orientation
- Horizontal
- Commercial License
- Further Information
Description
This captivating motion graphic presents an ethereal display of soft-focused, glowing purple particles, resembling dynamic bokeh lights, against a deep black background. The luminous orbs gracefully float and drift across the screen with a smooth, fluid motion, creating a serene and contemplative atmosphere. Varying in size and intensity, these abstract elements shimmer and gently pulse, adding a delicate sense of depth and movement to the composition. The continuous flow suggests a seamless loop, making it a versatile asset for extended use. This abstract animation is perfectly suited for enhancing a wide range of video projects, from elegant intros and atmospheric background visuals to dreamy transitions and stylistic overlays. It provides a sophisticated and calming aesthetic, ideal for presentations, event backdrops, meditation content, or any creative endeavor seeking a touch of luminous, modern elegance and subtle energy.